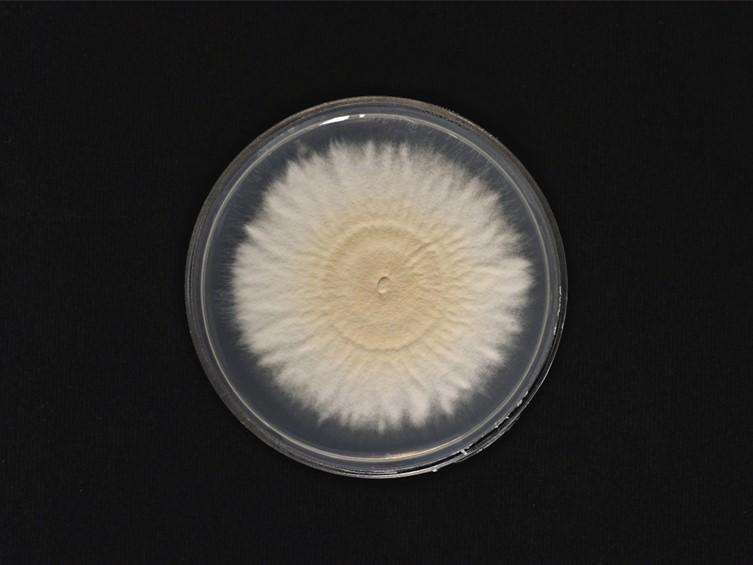
Cordyceps lepidopterorum

Holotype:
THAILAND, Chiang Mai Province, Kanlayaniwatthana District, 22 Nov. 2015, K. Tasanathai, S. Mongkolsamrit, D. Thanakitpipattana, W. Noisripoom, R. Promharn, P. Srikitikulchai, S. Wongkanoun, holotype BBH 40735, ex-type living culture TBRC 7263.
Habitat:
Leaf litter
Host:
Lepidopteran larva, cicada nymphs
Description:
 White powdery conidia covering the insect host. Conidiophores verticillate with
White powdery conidia covering the insect host. Conidiophores verticillate with  phialides in whorls of two to three. Phialides 5–8 × 4–5 μm, with a globose to flaskshaped basal portion, tapering into a distinct neck, 2–3 × 1 μm. Conidia in chains, hyaline, 1-celled, mostly broadly ellipsoidal or slipper-shaped, 1-celled, 6–10 × 3–4 μm, isaria-like.
phialides in whorls of two to three. Phialides 5–8 × 4–5 μm, with a globose to flaskshaped basal portion, tapering into a distinct neck, 2–3 × 1 μm. Conidia in chains, hyaline, 1-celled, mostly broadly ellipsoidal or slipper-shaped, 1-celled, 6–10 × 3–4 μm, isaria-like.  Stromata pale yellow (blackish brown after drying), simple, fusiform, fleshy, erect, protruding from the ground with several stromata loosely connected emerging from between the head and the thorax of the cicada nymph, 32–45 mm long. Fertile part on the terminal end c. 1/3 of the stroma. Mycelia scarce, whitish, covering the host, slightly rhizoidal in the soil joining together to form a compact stipe upon emerging from the soil. Perithecia
semi-immersed, ovoid, 400–650 × 300–400 μm.
Stromata pale yellow (blackish brown after drying), simple, fusiform, fleshy, erect, protruding from the ground with several stromata loosely connected emerging from between the head and the thorax of the cicada nymph, 32–45 mm long. Fertile part on the terminal end c. 1/3 of the stroma. Mycelia scarce, whitish, covering the host, slightly rhizoidal in the soil joining together to form a compact stipe upon emerging from the soil. Perithecia
semi-immersed, ovoid, 400–650 × 300–400 μm.  Asci cylindrical, 265–360 × 4–5 μm, ascus tip 2–3 μm.
Asci cylindrical, 265–360 × 4–5 μm, ascus tip 2–3 μm.  Ascospores whole, bola-shaped, 250–310 × 1 µm, terminal part fusiform 54–60 ×
1 μm, central part filiform, < 1 μm diam.
Ascospores whole, bola-shaped, 250–310 × 1 µm, terminal part fusiform 54–60 ×
1 μm, central part filiform, < 1 μm diam.
Culture characteristics:
Colony on PDA relatively fast-growing, ca 4.5 cm diam in 7 d at 25 °C, at first white with basal felt, becoming cream in the center within 14 d, cottony, with abundant conidial density, reverse unpigmented. Prostrate hyphae smooth, septate, hyaline, 2–3 μm diam. Conidiophores erect arising from prostrate hyphae, or on aerial hyphae, verticillate with phialides in whorls of two to three.
Colony on PDA relatively fast-growing, ca 4.5 cm diam in 7 d at 25 °C, at first white with basal felt, becoming cream in the center within 14 d, cottony, with abundant conidial density, reverse unpigmented. Prostrate hyphae smooth, septate, hyaline, 2–3 μm diam. Conidiophores erect arising from prostrate hyphae, or on aerial hyphae, verticillate with phialides in whorls of two to three.  Phialides on PDA 5–15 × 2–6 μm, with a globose to flask-shaped basal portion, tapering into a distinct neck, 1–6 × 1–2 μm.
Phialides on PDA 5–15 × 2–6 μm, with a globose to flask-shaped basal portion, tapering into a distinct neck, 1–6 × 1–2 μm.  Conidia on PDA in chains, hyaline, mostly broadly ellipsoidal or slippershaped, some curved, 1-celled, 9–14 × 3–5 μm. Chlamydospores and synnemata not observed.
Conidia on PDA in chains, hyaline, mostly broadly ellipsoidal or slippershaped, some curved, 1-celled, 9–14 × 3–5 μm. Chlamydospores and synnemata not observed.
Reference:
Mongkolsamrit S, Noisripooma W, Thanakitpipattana D, et al. (2018). Disentangling cryptic species with isaria-like morphs in Cordycipitaceae. Mycologia110: 230–257.
DOI: https://doi.org/10.1080/00275514.2018.1446651Species |
Strain |
Compound |
Pubchem CID |
Biological activity |
Reference |
|---|
|
Strain |
ITS | LSU | MF140765 | MF140766 | RPB1 | RPB2 | TEF1 | |
|---|---|---|---|---|---|---|---|---|
| BCC 12807 | MN296392 | - | - | - | - | - | - | - |
| BCC 12839 | MN296393 | - | - | - | - | - | - | - |
| BCC 79816 | MN296394 | - | - | - | - | - | - | - |
| BCC 79817 | MN296395 | - | - | - | - | - | - | - |
| TBRC 7263 | - | MF140765 | MF140699 | - | - | MF140768 | MF140792 | MF140819 |
| TBRC 7264 | - | MF140766 | MF140700 | - | - | MF140769 | MF140793 | MF140820 |